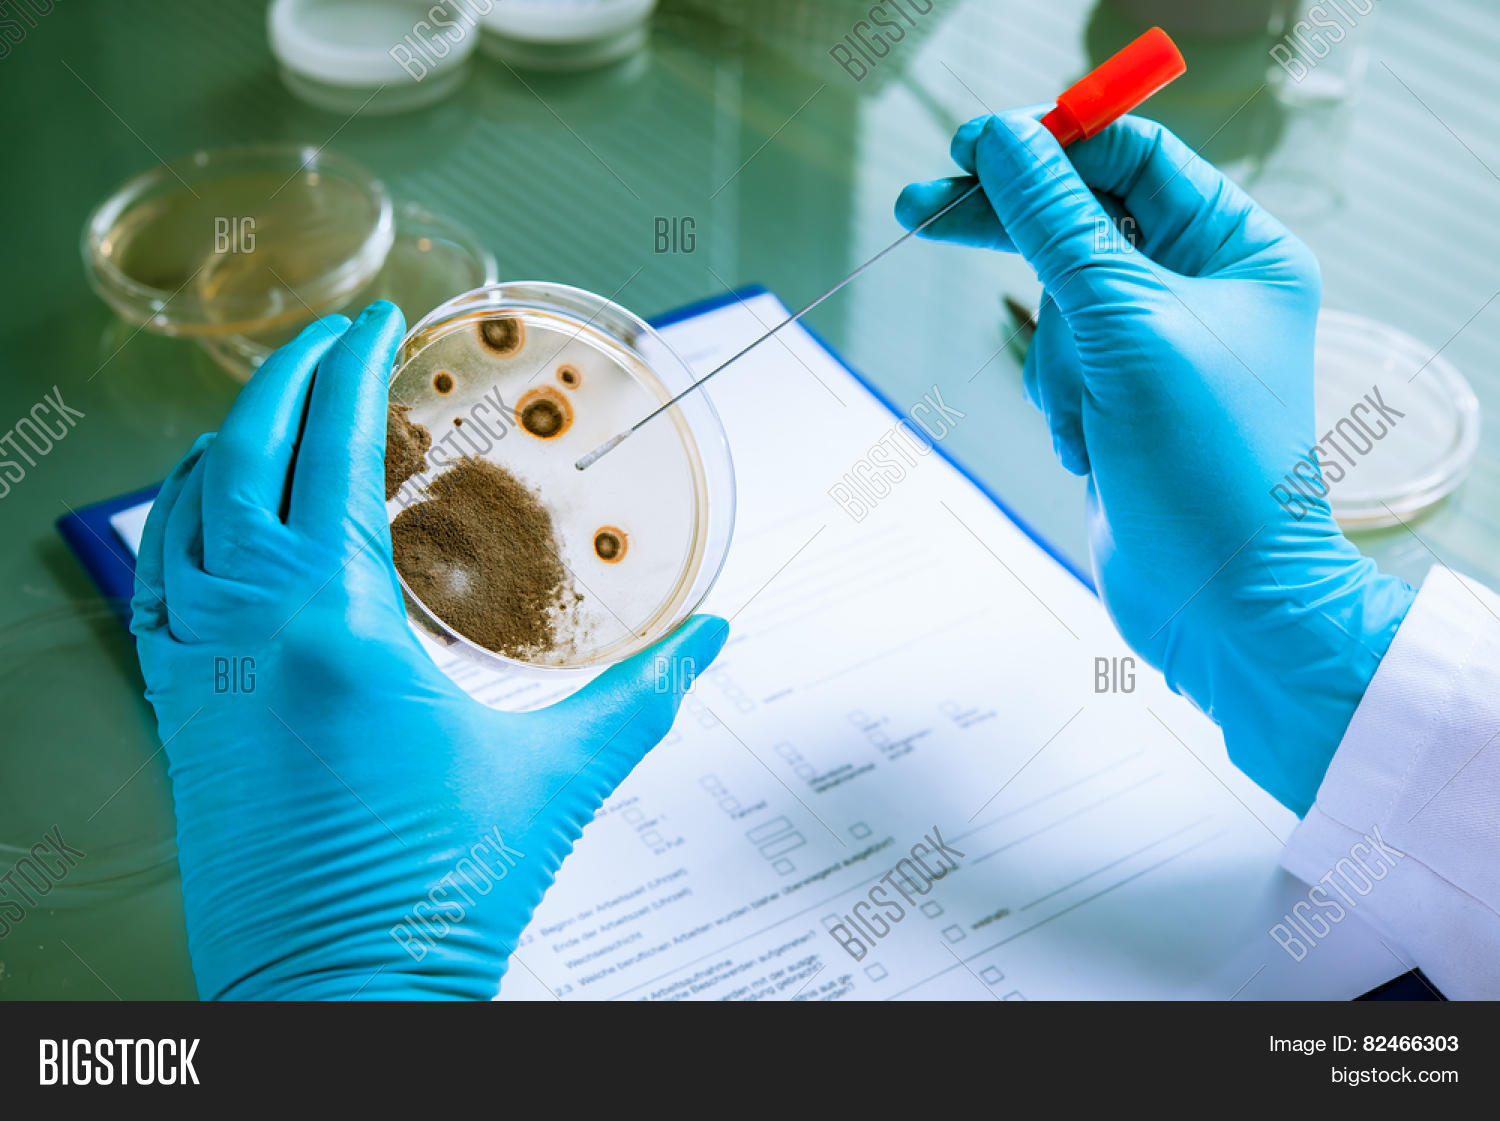

закрыть
изображение
Изображения
Germs growing on an agar plate in laboratory
| ID стокового фото: 82466303 |
| Авторское право: alexraths |
Скачивайте изображения любого размера по одной цене
| 5 изображенийв день | $0.53 / изображение | $79 |
| 10 изображенийв день | $0.33 / изображение | $99 |
| 50 изображений в месяц | $1.58 / изображение | $79 |
Кредиты действуют в течение макс. одного года.
| 10 Кредиты | $35 | |
| 25 Кредиты | сэкономьте 44% | $49 |
| 100 Кредиты | сэкономьте 52% | $169 |
| 500 Кредиты | сэкономьте 72% | $495 |
Сохранить предпросмотр этого изображения на Диск Google.